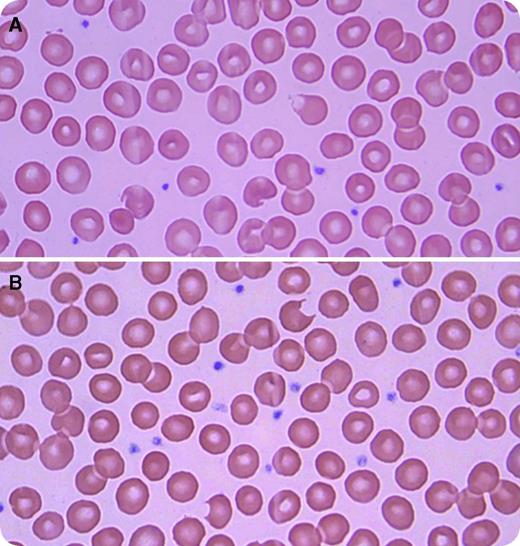
A 21-year-old African American man with HIV infection, well controlled with emtricitabine, rilpivirine, and tenofovir, presented with new onset of jaundice. The night before presenting, he took the sexual enhancement drug called “RUSH.” Initial investigations revealed a hemoglobin of 12.2 g/dL, mean corpuscular volume of 100 fL, reticulocyte count of 0.12 million/mm3, white blood count of 5200/mm3, platelets of 208 000/mm3, indirect bilirubin of 13.8 mg/dL, lactate dehydrogenase of 388 IU/L (normal level <241 IU/L), haptoglobin of <10 mg/dL, and negative direct Coombs test. A peripheral smear revealed bite cells and blister cells (panels A and B; original magnification ×100; Wright-Giemsa stain). The patient was treated supportively, and his hemolysis resolved within a few days. The level of glucose-6-phosphate-dehydrogenase (G6PD) during crisis was found to be severely decreased at 0.7 U/g (reference range, 9.9-16.6 U/g). A diagnosis of hemolytic anemia secondary to RUSH in a patient with G6PD deficiency was made. His hematologic parameters returned to baseline after the hemolytic crisis, but G6PD remained low. / RUSH is commonly used for sexual enhancement, especially in the homosexual population. Its active ingredient is amyl or butyl nitrite, which works primarily as a smooth muscle relaxant. Only a few cases have been reported of hemolytic anemia induced by RUSH. Apart from hemolysis, it can also induce methemoglobinemia, which can be fatal if not treated promptly.

A 21-year-old African American man with HIV infection, well controlled with emtricitabine, rilpivirine, and tenofovir, presented with new onset of jaundice. The night before presenting, he took the sexual enhancement drug called “RUSH.” Initial investigations revealed a hemoglobin of 12.2 g/dL, mean corpuscular volume of 100 fL, reticulocyte count of 0.12 million/mm3, white blood count of 5200/mm3, platelets of 208 000/mm3, indirect bilirubin of 13.8 mg/dL, lactate dehydrogenase of 388 IU/L (normal level <241 IU/L), haptoglobin of <10 mg/dL, and negative direct Coombs test. A peripheral smear revealed bite cells and blister cells (panels A and B; original magnification ×100; Wright-Giemsa stain). The patient was treated supportively, and his hemolysis resolved within a few days. The level of glucose-6-phosphate-dehydrogenase (G6PD) during crisis was found to be severely decreased at 0.7 U/g (reference range, 9.9-16.6 U/g). A diagnosis of hemolytic anemia secondary to RUSH in a patient with G6PD deficiency was made. His hematologic parameters returned to baseline after the hemolytic crisis, but G6PD remained low.
RUSH is commonly used for sexual enhancement, especially in the homosexual population. Its active ingredient is amyl or butyl nitrite, which works primarily as a smooth muscle relaxant. Only a few cases have been reported of hemolytic anemia induced by RUSH. Apart from hemolysis, it can also induce methemoglobinemia, which can be fatal if not treated promptly.
A 21-year-old African American man with HIV infection, well controlled with emtricitabine, rilpivirine, and tenofovir, presented with new onset of jaundice. The night before presenting, he took the sexual enhancement drug called “RUSH.” Initial investigations revealed a hemoglobin of 12.2 g/dL, mean corpuscular volume of 100 fL, reticulocyte count of 0.12 million/mm3, white blood count of 5200/mm3, platelets of 208 000/mm3, indirect bilirubin of 13.8 mg/dL, lactate dehydrogenase of 388 IU/L (normal level <241 IU/L), haptoglobin of <10 mg/dL, and negative direct Coombs test. A peripheral smear revealed bite cells and blister cells (panels A and B; original magnification ×100; Wright-Giemsa stain). The patient was treated supportively, and his hemolysis resolved within a few days. The level of glucose-6-phosphate-dehydrogenase (G6PD) during crisis was found to be severely decreased at 0.7 U/g (reference range, 9.9-16.6 U/g). A diagnosis of hemolytic anemia secondary to RUSH in a patient with G6PD deficiency was made. His hematologic parameters returned to baseline after the hemolytic crisis, but G6PD remained low.
RUSH is commonly used for sexual enhancement, especially in the homosexual population. Its active ingredient is amyl or butyl nitrite, which works primarily as a smooth muscle relaxant. Only a few cases have been reported of hemolytic anemia induced by RUSH. Apart from hemolysis, it can also induce methemoglobinemia, which can be fatal if not treated promptly.
For additional images, visit the ASH IMAGE BANK, a reference and teaching tool that is continually updated with new atlas and case study images. For more information visit http://imagebank.hematology.org.